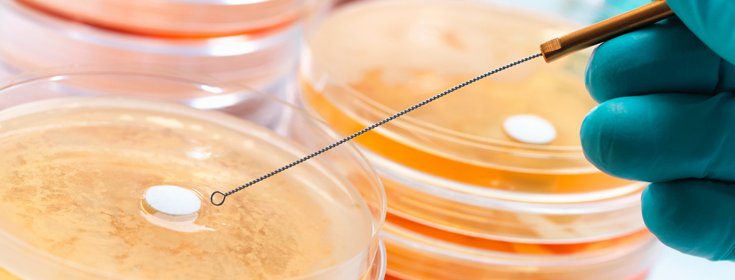

人员及设备在乳制品检验环节的重要作用
2023-08-09 19:25



乳制品检验工作对确保产品质量至关重要,检测人员及检测设备是乳制品质量检验环节中最具影响力的因素。 合格的乳制品检验员是保证检验工作质量的首要因素,因此必须运用各种手段提高检验人员的能力和素质。 1、开展知识和技能的教育培训,提高检验人员的检测技能。培训的具体内容应包括一些国际和国内公认的法律和标准,如IDF标准、AOAC公认标准、粮农组织的标准、企业内部标准、食品卫生法、测量法等。 2、在提高检测人员专业技能的同时也应加强检验人员的价值观、道德观、质量意识和文化素质,加强企业文化的宣传,提升检验人员的工作主动性,充分发挥积极性和创造性,增强岗位责任感,使检验人员在面对各种各样的工作条件时,都能克服困难及时做出正常判断,严格按照标准测试方法完成测试任务。 仪器设备是开展乳制品检验工作的硬件条件,也是检验系统误差的主要来源。目前,一些乳品企业拥有一些先进的仪器设备,能够准确、快速地提供各项检测数据。 基础文件应记录设备名称、制造商、规格、型号、使用时间、校准时间、维修状态等。设备运行记录应详细记录设备运行状态,以便跟踪仪器设备提供的检验数据。 许多用于乳制品检验的测量仪器,应定期根据规定的检定周期进行校准。验证和校准证书或检定证书应能追溯到国家测量标准。未经强制检定的计量、测试仪器和设备,应当定期进行自检。对检验和自检的仪器设备进行记录和标识,标识合格、准用和停用。这些仪器主要包括天平、砝码、滴定管、量瓶、刻度吸管、温度计、温度表、压力表、糖度表、乳脂表、分光光度计、PH计、牛奶多组分检测器等。 对重要的检验仪器,必须制定标准的操作规程,对操作人员进行培训后方可使用,经考核合格后方可使用。 化学试剂是检验所必需的。化学试剂纯度的选择、制备和贮存是保证检测质量的重要方面。 化学试剂一般可分为色谱纯试剂、超纯试剂、分析纯试剂、化学纯试剂、生物纯试剂等。试剂的纯度对检测结果的准确性有很大的影响。在使用试剂前,应根据不同的试验目的选择不同水平的试剂,以满足试验要求,避免浪费。作为标定的基准材料,必须采用优等标定;用于乳品化学和物理检验的试剂,一般分析纯;化学纯度可作为微生物检验的试剂。 注明试剂名称、浓度、制备剂、制备时间、有效时间等。 不正确的储存或使用试剂很容易导致变质和污染,这也是检验结果错误的主要原因之一。使用前需摇匀试剂。对于光敏试剂应放在棕色瓶子中,贮存在暗处;对于低沸点和挥发性试剂应放在阴凉处;剧毒药品必须严格保管,分开存放,确保安全。